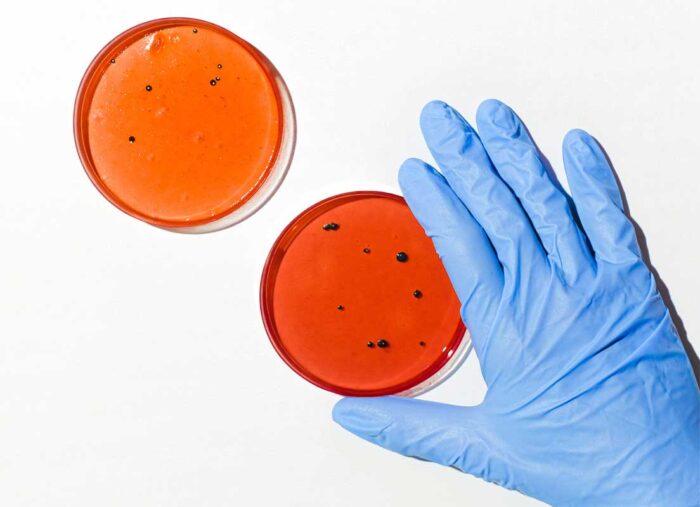

Este sitio web utiliza cookies y tecnologías similares para proporcionar el servicio, así como permitirnos mejorarlo, a través de la obtención de estadísticas sobre su uso, y otras finalidades.
Navegar por esta web implica necesariamente la utilización de cookies y tecnologías similares siempre y cuando sea necesario para su funcionamiento. Asimismo, para ciertas finalidades, las cookies y el almacenamiento local estarán sujetas a su previo consentimiento. Puede aceptar o rechazar las cookies mediante el sistema de configuración establecido y también es posible configurar el navegador para impedir su uso.